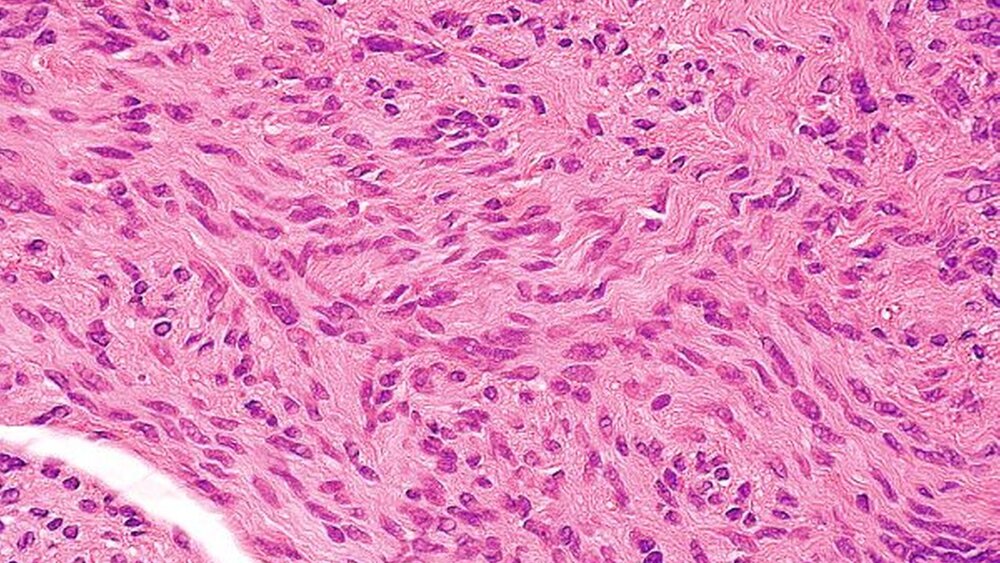

Apokrines Hidrozystom im Trigonum submandibulare
Kasuistik
Ein 49-jähriger, männlicher Patient ohne weitere Allgemeinerkrankungen wurde uns zur weiteren Abklärung einer Raumforderung im Trigonum submandibulare der linken Seite vorgestellt. Der Patient erinnerte sich, bereits vor Jahren einmal in dieser Region operiert worden zu sein, ohne jedoch genaue Angaben über das Ausmaß des Eingriffs oder die definitive Diagnose machen zu können (Abbildung 1). Die Vorstellung erfolgte, nachdem der Patient subjektiv über Monate eine Größenprogredienz festgestellt hatte, wobei die klinische Untersuchung der Motorik und Sensorik im Kopf- Hals-Bereich keine Auffälligkeiten erbrachte. Anamnestische Hinweise für das Vorliegen einer B-Symptomatik, wie Fieber, Nachtschweiß oder Gewichtsverlust, lagen nicht vor. Perimandibulär links war eine „Walnussgroße“, zum umgebenden Gewebe gut verschiebliche und nicht druckdolente Raumforderung palpierbar. Der Patient präsentierte sich zudem mit einem konservierend und prothetisch versorgten Restgebiss ohne Hinweise für einen dentogenen Fokus einer möglichen Infektion (Abbildung 2). In der zervikalen B-Mode-Sonografie (Abbildung 3) grenzte sich eine knapp drei Zentimeter große, nahezu homogen echoarme und komprimierbare Raumforderung vom umgebenden Weichgewebe ab, die dorsal eine Echoverstärkung aufwies und im Dopplermode keine gesteigerte Durchblutung erkennen ließ. Eine alio loco vom Hausarzt bereits initiierte Computertomografie erbrachte keinen Nachweis von Osteolysen oder pathologischen Lymphknotenvergrößerungen als Hinweise für Malignität der vorliegenden Raumforderung. Der Befund wurde über eine submandibuläre Inzision bei intraoperativem Monitoring des Ramus marginalis aus dem subcutanen Fettgewebe freipräpariert und in toto nach Ablösung von der Faszie des M. masseter exstirpiert. Bei Anschnitt des makroskopisch braun erscheinenden Tumors eröffnete sich ein Zystenlumen, aus dem sich reichlich dunkelbraunes Sekret entleerte (Abbildung 4). Zusätzlich wurde in gleicher Sitzung eine etwa 0,5 cm durchmessende derbe Papel im Bereich der Oberlippenschleimhaut spindelförmig in toto exzidiert, die nebenbefundlich zuvor im Rahmen der klinischen Untersuchung aufgefallen war. In der Histologie zeigte sich für die perimandibuläre zystische Raumforderung das typische Bild eines apokrinen Hidrozystoms mit einer von einem hoch prismatischen Epithel ausgekleideten Zyste und fokalen epithelialen papillären Epithelausstülpungen (Abbildung 5). Das Oberlippenexzidat erbrachte den Nachweis eines subepithelialen, spindelzelligen mesenchymalen Tumors mit intrazytoplasmatischer Reaktion gegen S100, welches dem histologischen Bild eines peripheren Neurinoms (Schwannom) entspricht (Abbildung 6). In beiden Fällen stellte die vollständige Exzision die Therapie der Wahl dar, und der Patient ist seither rezidivfrei.
Diskussion
Hidrozystome sind selten auftretende, benigne Schweißdrüsen-Tumoren und werden zumeist periorbital und im Bereich der Wangenregion lokalisiert. Über die Pathogenese wird zwischen zwei Subtypen differenziert. Dem ekkrinen Hidrozystom liegt eine Dilatation des Drüsenlumens nach Blockade des Drüsenausführungsganges mit konsekutiver Schweißretention zugrunde, während beim apokrinen Subtyp eine Proliferation des Drüsenepithels für die Größenzunahme verantwortlich ist. Daher ist besonders beim ekkrinen Subtyp bei Zunahme der Schweißsekretion eine Größenzunahme beobachtbar [Khashayar Sarabi et al., 2006]. Oftmals gestaltet sich eine histologische Unterscheidung zwischen den beiden Subtypen schwierig [de Viragh PA et al., 1997] und ist für die Therapie letztlich nicht von Bedeutung. Jedoch sollte vor definitiver Therapie durch eine Probebiopsie immer die sichere Abgrenzung zu Basaliomen, Keratoakanthomen und Hämagiomen beziehungsweise im Falle der pigmentierten Hidrozystome (Hidrozystoma noir) zum malignen Melanom erfolgen [Khashayar Sarabi et al., 2006]. Klinisch imponieren Hidrozystome als hautfarbene bis bläulich-schwarze Raumforderungen (Tyndall-Effekt), die überwiegend solitär im Kopf- und Halsbereich vorkommen. Das Geschlechterverhältnis ist bei den singulären Entitäten (Robinson-Typ) ausgeglichen, während für multipel auftretende Hidrozystome (Smith–Typ) eine Dominanz beim weiblichen Geschlecht gesehen wird [Khashayar Sarabi et al., 2006]. Weiterhin ist über das Auftreten von Hydrozystomen im Zusammenhang mit genetisch bedingten Syndromen wie Gorlin-Goltz-Syndrom und Schopf-Schulz-Passarge-Syndrom berichtet worden. Ebenso wird anscheinend durch die Hyperhidrose bei Patienten mit Hyperthyreose (Grave´s disease, M. Basedow) das Auftreten von Hidrozystomen gefördert [Khashayar Sarabi et al., 2006]. Während vereinzelt auftretende Hidrozystome meist problemlos chirurgisch exzidiert werden können, gestaltet sich die Therapie von multiplen Hidrozystomen im ästhetischen Bereich aufgrund der Narbenbildung schwierig. Die topische Anwendung von Scopolamin und Atropin wird im Ergebnis unterschiedlich diskutiert und oftmals stehen die systemischen Nebenwirkungen im Vordergrund. Aktuelle Einzelfallberichte dokumentieren hingegen positive Ergebnisse durch den Einsatz von Diodenlaser, der ggf. auch in mehreren Sitzungen durchführbar ist [Echague AV et al., 2008]. In der vorliegenden Kasuistik ließ zunächst die anatomische Lage prima vista an einen infektiösen Logenabszess denken, für den es aufgrund der langen Anamnese sowie der klinischen und radiologischen Untersuchung jedoch letztlich keinen Anhalt gab. Differentialdiagnostisch kamen Speicheldrüsentumoren der Glandula submandibularis beziehungsweise submandibulär gelegene Lymphome in Frage, die jedoch durch die Bildgebung ausgeschlossen wurden. Interessant erscheint letztlich die histologische Zuordnung des tief subkutan gelegenen Tumors zu den apokrinen Hidrozystomen, da sowohl Lage als auch Größe im Vergleich mit den in der Literatur beschriebenen als untypisch anzusehen ist. Abschließend wurde bei dem Patienten ein weiterer Tumor entdeckt. Das zeigt, dass selbst offensichtliche Befunde nicht von einer konsequent durchgeführten systematischen Untersuchung ablenken sollten.
Keyran SaghebDr. Dr. Maximilian MoergelProf. Dr. Dr. Wilfried WagnerKlinik für Mund-, Kiefer- und GesichtschirurgieKlinikum der Johannes Gutenberg-UniversitätAugustusplatz 255131 Mainz